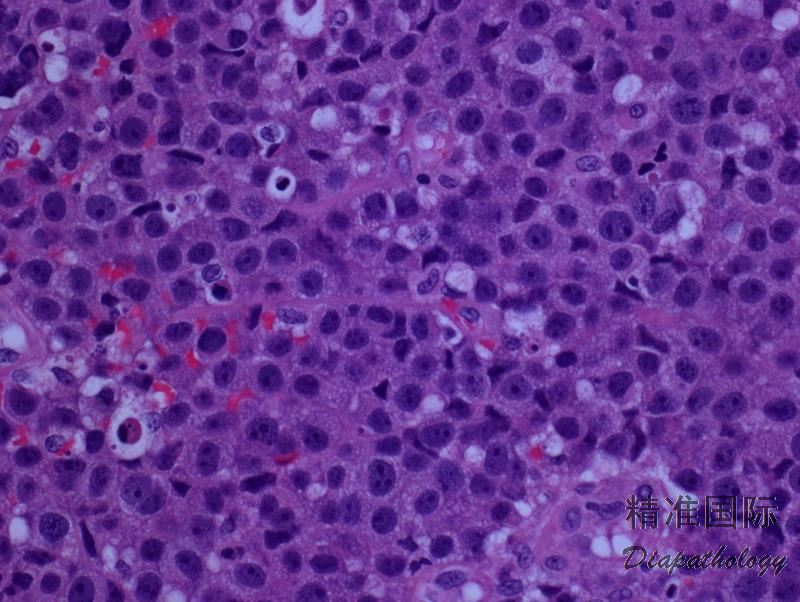

原发皮肤间变大细胞淋巴瘤
Primary Cutaneous Anaplastic Large Cell Lymphoma, C-ALCL
概述:
原发性皮肤 CD30 阳性 T 细胞淋巴组织增殖性疾病包括原发性皮肤间变性大细胞淋巴瘤(C-ALCL)、淋巴瘤样丘疹病(LyP)和交界性病变。这些疾病代表了一个连续的病变谱系,在形态、免疫、和遗传学上常相互重叠。因此,临床表现和过程对确诊至关重要。有些病例,尽管经病理和临床综合研究,还是一时无法区分开 C-ALCL 和 LyP(交界性病变)。 C-ALCL 的组织学特征为弥漫大细胞增生,具间变样、多形性或免疫母样细胞形态,表达 CD30。 需除外系统性 ALCL 累及皮肤;如同时有 MF 或 MF 病史,则需考虑 MF 伴大细胞转化。
诊断要点:
中位发病年龄 60 岁(儿童偶有报道),主要累及躯干、面部、和四肢。表现为孤立性结节,也可多发(20%病例),常伴溃疡。偶尔病灶自行消失,但复发。少数病例(10%)可以扩散至皮外部位,主要是局部淋巴结。
肿瘤细胞弥漫浸润,主要累及真皮层,可延及皮下组织,但有时见亲表皮浸润,特别是有 DUSP22-IRF4 病例。病灶周围可见少量背景炎性细胞,但如有溃疡,则常伴有丰富炎性细胞常(类似 LyP)。罕见病例含大量中性粒细胞(中性粒细胞富有亚型)。
多数病例肿瘤细胞呈现间变性形态(园或椭圆形核、核不规则、显著嗜伊红核仁、丰富胞质),但也可呈现多形性或免疫母样细胞形态。
免疫表型:肿瘤细胞表达 CD30(>75%的细胞)和细胞毒分子,常表达 CD4,但其它 T 细胞相关抗原不定;偶见 CD8+/CD4-或 CD4-/CD8-,或无任何 T 相关抗原表达。EMA 和 ALK 一般阴性。约 40%病例 CD15+,MUM1 几乎总是阳性。PAX5 阴性,EBER 阴性。
大多数病例有 TCR 基因克隆性重排。绝大多数病例无 ALK 基因易位。有极少数报道有 t(2;5)或免疫组化 ALK 阳性(核或核+胞浆),这些病例预后好。25%病例(以及很少数 LyP 病例)有 DUSP22-IRF4 易位。

免疫组织化学染色:
肿瘤细胞表达 CD30 和细胞毒分子,常表达 CD4,但其它 T 细胞相关抗原不定;EMA 和 ALK 一般也阴性(极少报道儿童 C-ALCL ALK+)。
鉴别诊断:
- 系统性间变大细胞淋巴瘤(ALCL)累及皮肤 :存在系统性 ALCL 的病史或证据,皮肤病变不会自行消失,肿瘤细胞常表达 EMA,部分病例 ALK+(多见于年轻患者)。
- 淋巴瘤样丘疹病 (LyP):C 型 LyP 形态学和免疫表型可与 C-ALCL 重叠。同时存在不同发展阶段的皮肤病变及某一病变常在 3-12 周自行消失支持 LyP。
- 蕈样霉菌病(MF)大细胞转化 :转化大细胞可以 CD30+, 与 C-ALCL 难以鉴别。MF 病史或同时存在不同阶段的典型 MF 皮肤病变(斑片、斑块)或组织学见到残存的典型 MF 细胞及亲表皮浸润,有助诊断。
- 原发性皮肤 γ/δT 细胞淋巴瘤 (Primary cutaneous γ/δT cell lymphoma):临床表现为侵袭性,肿瘤主要侵犯四肢可也累及全身皮肤和内脏。肿瘤细胞可浸润表皮、真皮或皮下,表达 CD3. CD56. CD2. TCRδ,不表达 CD4. CD8(少数+)、CD5. βF1。
- 外周 T 细胞淋巴瘤,非特指 (PTCL,NOS):累及皮肤时,表现为斑块或肿瘤结节。组织学表现肿瘤细胞主要弥漫或结节性侵犯真皮,形态大小不定,CD30 阴性或局灶阳性,患者有系统性/结性 T 细胞淋巴瘤病史。
预后:
10 年存活期达 90%,多灶性或局部淋巴累及不影响预后。
